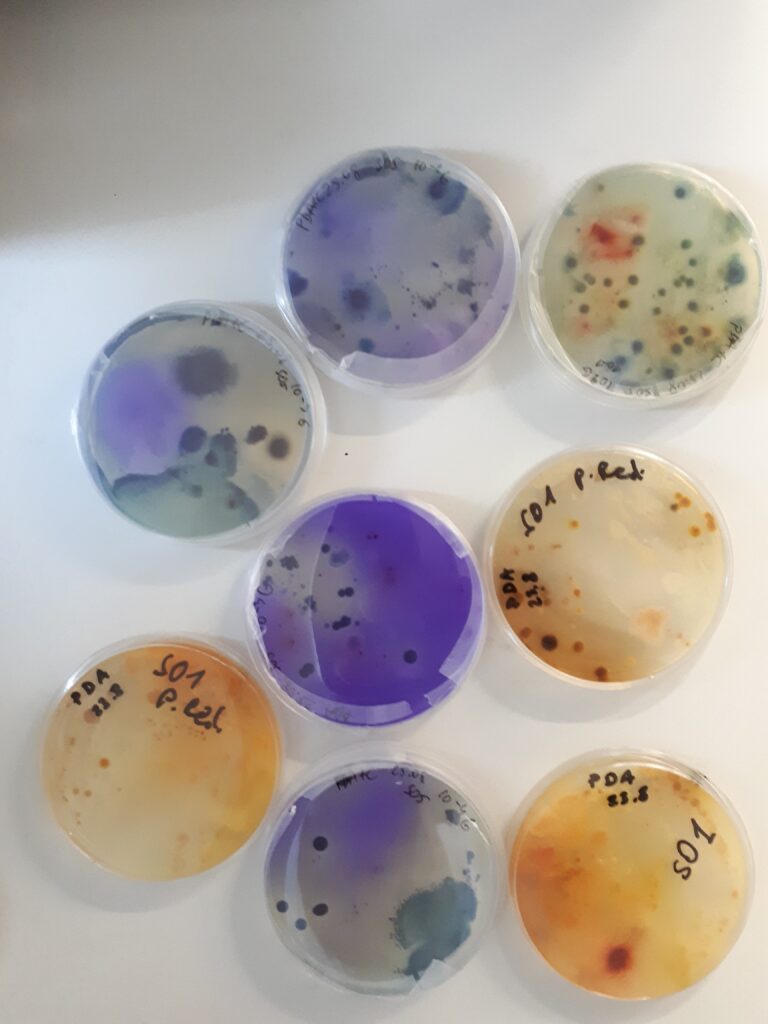
biotechnologia przemysłowa; próbki; hodowle

STUDIA I STOPNIA
Czas trwania:
3,5-letnie
Rozpoczęcie:
semestr zimowy – 1 października 2026 r.
Specjalność:
- biotechnologia przemysłowa i w ochronie środowiska
Biotechnolog inżynierem przyszłości
Procesy biotechnologiczne towarzyszą ludzkości od zarania dziejów i są nieodzownym elementem wielu gałęzi przemysłu, m.in. piekarnictwa, winiarstwa, ziołolecznictwa, mleczarstwa. Odkąd człowiek nauczył się świadomie wytwarzać bioprodukty
w oparciu o potencjał drzemiący w organizmach żywych, dla biotechnologii otworzyły się nieograniczone możliwości!
Biotechnologia to dziedzina interdyscyplinarna, ściśle powiązana
z wieloma naukami, m.in. biologią, biochemią, chemią i mikrobiologią, a także genetyką i inżynierią metaboliczną.
Jako wykładowcy, dbamy o wszechstronne wykształcenie naszych Studentów. Absolwenci kierunku Biotechnologia przemysłowa są przygotowani do pracy na stanowiskach związanych z organizacją
i prowadzeniem procesów biotechnologicznych w przemyśle. Ponadto jako wysokiej rangi specjaliści znajdują zatrudnienie w branży spożywczej, rolniczej, medycznej, farmakologicznej oraz w ochronie środowiska. Nasi Studenci są merytorycznie i praktycznie przygotowani do pracy w nowoczesnych laboratoriach badawczych, posiadają umiejętność współpracy ze specjalistami z różnych dziedzin. Nabyte w procesie kształcenia kwalifikacje predysponują ich do kierowania zasobami ludzkimi a także prowadzenia działalności gospodarczej.

Dlaczego biotechnologia przemysłowa ?
Jest to intensywnie rozwijająca się i nowoczesna dziedzina szerokorozumianego przemysłu. Ukierunkowana jest na tworzenie rozwiązań zgodnych z ideą zrównoważonego rozwoju oraz dbającą o jakość życia przyszłych pokoleń. Biotechnologia przemysłowa wykorzystuje systemy biologiczne w produkcji przemysłowej i ochronie środowiska. Opracowane w ten sposób technologie zastępują przestarzałe już rozwiązania oparte na dotychczasowych rozwiązaniach.
Specjalność studiów
Biotechnologia przemysłowa i w ochronie środowiska
Absolwenci kierunku Biotechnologia przemysłowa mają uporządkowaną, podbudowaną teoretycznie wiedzę w zakresie nauk przyrodniczych. Potrafią oznaczać właściwości fizykochemiczne związków chemicznych oraz materiałów i surowców stosowanych w biotechnologii. Zdobywają praktyczne umiejętności do planowania i prowadzenia eksperymentów z zakresu biotechnologii przemysłowej, jak również ich interpretacji. Posługują się programami komputerowymi, wspomagającymi realizację zadań typowych dla działalności inżynierskiej w zakresie biotechnologii. Posiadają umiejętność praktycznego korzystania ze zdobytej wiedzy oraz stosują się do zasad dobrej praktyki laboratoryjnej, higienicznej oraz produkcyjnej. Potrafią w działaniach zawodowych postępować z wymogami aktualnych norm i przepisów prawnych obowiązujących w przemyśle oraz w ochronie środowiska, zgodnie z zasadą zrównoważonego rozwoju.
Studia to nie tylko kształcenie
Praktyki i praca
Praktyki zawodowe są nieodzownym elementem zdobywania wiedzy praktycznej. Studenci podczas odbywania praktyk mają możliwość poznania struktury organizacyjnej danego zakładu pracy, specyfiki jego działania, wdrażanych (bio)technologii i procedur analitycznych. Dodatkowo w toku studiów Studenci odbywają wizyty studyjne w różnych zakładach przemysłowych i ośrodkach badawczych, z którymi współpracuje Wydział Inżynierii i Technologii Chemicznej.
Wiedza, kompetencje i umiejętności nabyte podczas studiów przygotowują naszych Absolwentów do podjęcia działalności zawodowej w przemyśle biotechnologicznym i pokrewnych (m.in. chemicznym, medycznym, spożywczym, w ochronie środowiska) oraz do prowadzenie własnej działalności gospodarczej.
